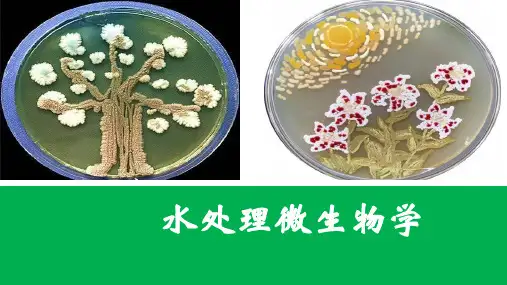

微生物的生长和繁殖
- 格式:ppt
- 大小:5.78 MB
- 文档页数:10




微生物的生长与繁殖微生物是指肉眼无法直接观察到的微小生物体,包括细菌、真菌、病毒等。
微生物的生长与繁殖是一个非常重要的过程,它们对生态系统的平衡、环境保护、医学研究等领域都有着深远的影响。
本文将从微生物的生长环境、影响微生物生长与繁殖的因素以及微生物的繁殖方式等方面进行探讨。
一、微生物的生长环境微生物的生长环境非常广泛,它们可以存在于土壤、水体、空气中,甚至可以在极端环境比如高温、高压、极寒等条件下存活。
微生物最适宜生长的环境被称为生长有限因素(Limiting factors),这包括适宜的温度、pH值、氧气含量、养分可获得性等。
例如,细菌在37摄氏度左右的温度下生长最快,而酵母菌则对酸性环境更为适应。
二、影响微生物生长与繁殖的因素除了生长有限因素外,还有一些其他因素会影响微生物的生长与繁殖。
其中最重要的因素之一是营养物质的可获得性。
微生物需要一定的碳、氮、磷等元素来进行生物合成和能量代谢,当这些养分不足或缺乏时,微生物的生长速率将受到限制。
此外,水分、盐度、压力等也会影响微生物的生长与繁殖。
三、微生物的繁殖方式微生物的繁殖方式可以分为两种:无性繁殖和有性繁殖。
无性繁殖是指微生物通过自我复制来增加数量。
其中最常见的繁殖方式是二分裂(binary fission),即细菌细胞通过不断分裂形成两个相同的细菌细胞。
这个过程通常包括细胞质分裂、DNA复制和细胞分裂三个步骤。
相比之下,真菌则通过产生分生孢子(spores)来进行无性繁殖,病毒则依赖于寄生宿主细胞来进行繁殖。
有性繁殖是指微生物通过与同种或异种微生物的结合来增加遗传变异和多样性。
然而,大部分微生物并不具备有丝分裂(mitosis)等真正的有性繁殖方式。
相反,它们通过水平基因转移(horizontal gene transfer)来产生变异。
这包括共轭(conjugation)、转化(transformation)和转导(transduction)等过程,这些过程允许微生物之间交换遗传物质。

什么是微生物的繁殖和生长(二)引言概述:微生物的繁殖和生长是微生物学中的重要概念。
在微生物学中,繁殖指的是微生物个体数目的增加,而生长则是指微生物个体的大小、重量以及活动能力的增加。
本文将以引言、正文和总结的方式,阐述微生物的繁殖和生长的相关知识。
正文:1. 繁殖方式:- 二分裂:微生物通过二分裂的方式进行繁殖,其中一个微生物个体分裂为两个完全相同的个体。
- 胞内增殖:一些微生物可以在一个宿主细胞内进行增殖,形成内共生现象。
- 配子生殖:某些微生物可以通过配子结合的方式进行繁殖。
2. 繁殖速率:- 繁殖速率受到环境因素、营养、温度和氧气等条件的影响。
- 快速繁殖的微生物通常具有较高的代谢活性和繁殖速率,而慢生长微生物则相对较低。
3. 影响繁殖的因素:- 营养:微生物繁殖需要合适的营养物质,包括碳源、氮源和微量元素等。
- 温度:不同的微生物有不同的最适生长温度,并在该温度下繁殖最为迅速。
- pH 值:微生物对 pH 值的适应能力各不相同,适宜的 pH值有利于微生物的繁殖。
4. 生长曲线:- 存活期:微生物在营养环境中进入存活期,在此期间微生物个体数目保持相对稳定。
- 密度依赖:当微生物个体数目达到一定阈值后,资源的限制将导致生长速率下降。
- 死亡期:当资源严重不足时,微生物个体数目将开始减少,进入死亡期。
5. 控制繁殖和生长的方法:- 抗生素:抗生素是一种常用的抑制微生物繁殖和生长的方法。
- 温度控制:通过控制温度可以有效控制微生物的繁殖和生长。
- 无菌操作:无菌操作可防止微生物的传播和繁殖。
总结:微生物的繁殖和生长是微生物学中重要的概念。
不同的微生物根据其特有的繁殖方式和生长条件,在不同的营养环境中会表现出不同的生长行为。
了解微生物的繁殖和生长机制对于控制微生物的增殖以及预防微生物相关疾病等方面具有重要意义。


什么是微生物的繁殖和生长(一)引言概述:微生物是一类广泛存在于自然界中的微小生物体,包括细菌、真菌、病毒和原生动物等。
微生物的繁殖和生长是其生命周期中重要的过程,对于了解微生物的生态学与应用具有重要意义。
本文将就微生物的繁殖和生长进行阐述。
正文内容:一、微生物的繁殖方式1. 二分裂:细菌和许多单细胞真菌通过二分裂方式进行繁殖。
a. 准备阶段:细胞增加大小并复制遗传物质。
b. 分裂阶段:细菌或真菌细胞分裂为两个完整的细胞。
2. 管状繁殖:某些真菌通过产生管状结构将营养物质输送到其他细胞。
3. 减数分裂:原生动物等一些微生物通过减数分裂繁殖。
二、微生物的繁殖速率受到的影响因素1. 温度:不同微生物对温度的适应范围不同,影响其繁殖速率。
2. pH值:酸性或碱性环境可能影响微生物的繁殖速率。
3. 营养物质:微生物需要适量的碳源、氮源和微量元素来维持其生长和繁殖。
4. 水分:水分对微生物的繁殖和生长至关重要。
5. 氧气:微生物的需氧性或厌氧性影响其在不同氧气条件下的繁殖速率。
三、微生物的生长曲线1. 潜伏期:微生物适应环境并准备进行繁殖的时间段。
2. 对数增长期:微生物以指数方式增长,此时繁殖速率最快。
3. 平稳期:微生物繁殖速率与死亡速率达到平衡,细菌数量保持相对稳定。
4. 降解期:环境中的营养物质或其他条件不再适宜微生物繁殖,细菌数量逐渐减少。
四、微生物的控制方法1. 无菌技术:通过采取无菌操作和环境控制减少微生物繁殖。
2. 温度控制:适当的温度控制可以抑制微生物繁殖,如制冷或加热。
3. 化学消毒:使用化学物质消除或抑制微生物的生长和繁殖。
4. 高压灭菌:利用高压力来杀灭或抑制微生物的繁殖。
5. 光照控制:某些微生物对光照敏感,适当的光照控制可以减少其繁殖。
五、总结微生物的繁殖和生长是其生命周期中重要的过程,对于了解微生物的生态学与应用具有重要意义。
通过了解微生物的繁殖方式、繁殖速率受到的影响因素、生长曲线以及控制方法,我们可以更有效地控制微生物的生长和繁殖,避免微生物带来的不良影响。

微生物的生长与繁殖微生物是一类微小的生物体,包括细菌、真菌、病毒等多种类型。
它们存在于自然界的各个角落,广泛影响着生态系统的平衡和人类的健康。
微生物的生长与繁殖是其生命过程中至关重要的一部分,本文将详细介绍微生物的生长与繁殖的过程与条件。
一、微生物的生长过程微生物的生长分为三个主要阶段:适应期、指数增长期和平稳期。
适应期是微生物在营养环境中要适应并获得最适条件的过程。
微生物吸收营养物质,通过调节内部代谢活动,逐渐适应新的环境。
适应期的时间长短取决于微生物种类和环境因素。
指数增长期是微生物生长的最快阶段,此阶段微生物以无性生殖的方式迅速繁殖。
在适宜的温度、溶液pH值和适当的营养物质条件下,微生物的数量呈几何倍数增长。
这是由于微生物在生长过程中会进行二分裂,每个新的细胞也会继续进行二分裂。
平稳期是指微生物数量达到最大值后进入的生长缓慢的阶段。
此时,微生物数量趋于稳定,细胞死亡和分裂的速率相等。
微生物的生理代谢逐渐减缓,营养物质逐渐耗尽,产生的代谢产物也逐渐积累,导致环境的恶化。
二、微生物生长与繁殖的条件1. 温度微生物对温度非常敏感。
每个微生物种类都有其最适宜的生长温度范围。
通常将微生物根据其适应温度的范围分为:嗜寒微生物、嗜热微生物和中温微生物。
温度过高或过低都会抑制微生物的生长和繁殖。
2. pH值不同的微生物对pH值也有不同的适应范围。
大多数细菌的最适pH值集中在6-8之间,而真菌的最适pH值一般在5-6之间。
当环境中的pH值偏离微生物的最适pH值,会影响其酶的活性和细胞膜的稳定性,从而抑制了微生物的生长和繁殖。
3. 营养物质微生物对营养物质的需求也是生长的重要条件之一。
微生物需要碳源、氮源、矿物元素和其他有机物来满足其生存和繁殖所需的能量和原料。
不同的微生物在对营养物质有不同的需求,因此提供适宜的营养物质是促进微生物繁殖的关键。
4. 氧气氧气是微生物生长和繁殖的重要因素之一。
有些微生物需要氧气进行呼吸作用,被称为好氧微生物;而有些微生物则不能耐受氧气,被称为厌氧微生物。

微生物的生长繁殖方式微生物是我们身边不可缺少的一部分,它们生长繁殖的方式主要分为三种,即分裂繁殖、孢子繁殖和性繁殖。
本文将分别介绍这三种繁殖方式,帮助读者更深入地了解微生物。
一、分裂繁殖分裂繁殖是微生物普遍采用的一种繁殖方式。
其基本原理是通过细胞分裂的过程不断增加细胞数量。
通常,细胞在正常状态下会快速增长,其繁殖速度取决于环境条件(如温度、营养物质的丰富程度等)。
在分裂繁殖过程中,细胞会首先复制自己的DNA,接着将复制的DNA分配给两个女儿细胞。
然后,这两个女儿细胞会继续分裂,并继续传承下去。
分裂繁殖的优点是速度快,能在短时间内增加微生物数量,但也容易导致基因变异或产生抗药性菌株,是限制其应用的因素之一。
二、孢子繁殖孢子繁殖是一种微生物繁殖的形式,通常在条件恶劣的环境下使用。
这种繁殖方式中,微生物会产生孢子将其DNA包裹,并在达到某种条件时从孢子中释放出来。
孢子具有高度耐受性并且可以在不利条件下存活很长时间。
这种繁殖方式的优点是,在面临不利环境时可以快速转化为休眠状态,等待环境恢复后再次生长。
例如,细菌的芽胞可以在高温或低温、干燥或缺氧等条件下保护其DNA 并快速转入休眠状态。
孢子繁殖是微生物保持种群数量的一种策略,也可以用于微生物在不同的环境中进行生物质转化。
三、性繁殖性繁殖是一种微生物繁殖方式,仅限于某些特定微生物。
性繁殖能够导致基因重排和基因突变。
在性繁殖中,两个单细胞生物相互结合并交换基因,从而产生新的群体。
此过程有时称为杂交。
对于某些微生物,如真菌和原生动物,性繁殖是其主要的繁殖方式。
与分裂繁殖相比,性繁殖严格要求某些特定的环境,如群体密度、营养素的丰富程度等。
这种方式下的细胞通常相对较大小,通常在某些明显的结构体中发现(如杆菌)。
总结:微生物繁殖方式有多种不同的类型。
分裂繁殖是最常见的繁殖方式,可以快速增加微生物数量。
孢子繁殖是微生物在不良环境下进行休眠的一种策略,并具有强大的耐受性。
微生物的生长和繁殖近年来,随着微生物研究的不断深入,人们开始逐渐认识到微生物对于我们生活的重要性。
微生物的生长和繁殖是影响微生物在环境中数量变化的关键过程。
本文将探讨微生物的生长与繁殖的原理和条件,并探讨其在人类生活中的应用。
一、微生物生长的原理微生物的生长是指微生物数量的增加过程。
微生物生长的原理主要包括以下几个方面。
1. 细胞分裂微生物的生长主要是通过细胞的分裂完成的。
细菌的细胞分裂方式通常是二分裂,即一个细菌细胞分裂成两个细菌细胞;而酵母菌等真菌则通过芽生和分裂的方式繁殖。
2. 营养摄取微生物的生长需要摄取营养物质来供给细胞分裂和代谢所需。
不同种类的微生物对于营养物质的需求有所差异,有些微生物可以利用有机物质作为能源和碳源,有些则可以利用无机物质进行化能合成。
3. 外界环境条件微生物的生长与外界环境条件密切相关。
温度、pH值、氧气浓度和营养物质的丰度等因素都会影响微生物的生长速度和繁殖能力。
不同种类的微生物对于这些环境条件的要求各异,有些微生物对环境条件的适应能力很强,能在极端的环境中存活和繁殖。
二、微生物生长的条件为了促进微生物的生长和繁殖,我们需要提供一定的环境条件。
以下是影响微生物生长的几个关键因素。
1. 温度温度是影响微生物生长的最重要的因素之一。
不同微生物对温度的适应能力不同,有些微生物可以在极高或极低的温度下生长,而有些只能在较为温暖的环境中生存。
2. pH值pH值是指溶液的酸碱程度,也是影响微生物生长的重要因素之一。
不同的微生物对pH值的要求也有所差异,有些微生物对酸性环境更适应,而有些则对碱性环境更适应。
3. 氧气浓度氧气是微生物生长和繁殖过程中的重要因子之一。
有些微生物需要氧气进行呼吸代谢,被称为需氧菌;有些则能在无氧条件下进行代谢和繁殖,被称为厌氧菌。
还有一些微生物则具有较强的适应能力,既可以进行需氧呼吸,也可以进行厌氧呼吸。
4. 营养物质微生物的生长离不开适量的营养物质供给。
微生物的生长和繁殖微生物在适宜的环境条件下,不断地吸收营养物质,并按照自己的代谢方式进行代谢活动,如果同化作用大于异化作用,则细胞质的量不断增加,体积得以加大,于是表现为生长。
简单地说,生长就是有机体的细胞组分与结构在量方面的增加。
单细胞微生物如细菌,生长往往伴随着细胞数目的增加。
当细胞增长到一定程度时,就以二分裂方式,形成两个基本相似的子细胞,子细胞又重复以上过程。
在单细胞微生物中,由于细胞分裂而引起的个体数目的增加,称为繁殖。
在一般情况下,当环境条件适合,生长与繁殖始终是交替进行的。
从生长到繁殖是一个由量变到质变的过程,这个过程就是发育。
微生物处于一定的物理、化学条件下,生长发育正常,繁殖速率也高;如果某一或某些环境条件发生改变,并超出了生物可以适应的范围时,就会对机体产生抑制乃至杀灭作用。
、细菌纯培养的群体生长规律大多数细菌的繁殖速度都很快,大肠杆菌在适宜条件下,每20分钟左右便可分裂一次,如果始终保持这样的繁殖速度,一个细菌在48小时内,其子代群体将达到无法想象的数量。
?然而,实际情况并非如此。
将少量单细胞纯培养接种到一恒定容积的新鲜液体培养基中,在适宜的条件下培养,定时取样测定其细菌含量,可以看到以下现象:开始有一短暂时间,细菌数量并不增加,随之细菌数目增加很快,既而细菌数又趋稳定,最后逐渐下降。
如果以培养时间为横坐标,以细菌数目的对数或生长速度为纵坐标作图,可以得到一条曲线,称为繁殖曲线,通常又称为生长曲线。
生长曲线代表了细菌在新的适宜的环境中生长繁殖直至衰老死亡全过程的动态变化。
根据细菌生长繁殖速率的不同,可将生长曲线大致分为延迟期、对数期、稳定期和衰亡期四个阶段。
(1)延迟期:少量细菌接种到新鲜培养基后,一般不立即进行繁殖,生长速度近于零。
因此在开始一段时间,细菌数几乎保持不变,甚至稍有减少。
这段时间被称为延迟期,又称为迟缓期、调整期或滞留适应期。
处于延迟期细菌细胞的特点是分裂迟缓、代谢活跃。